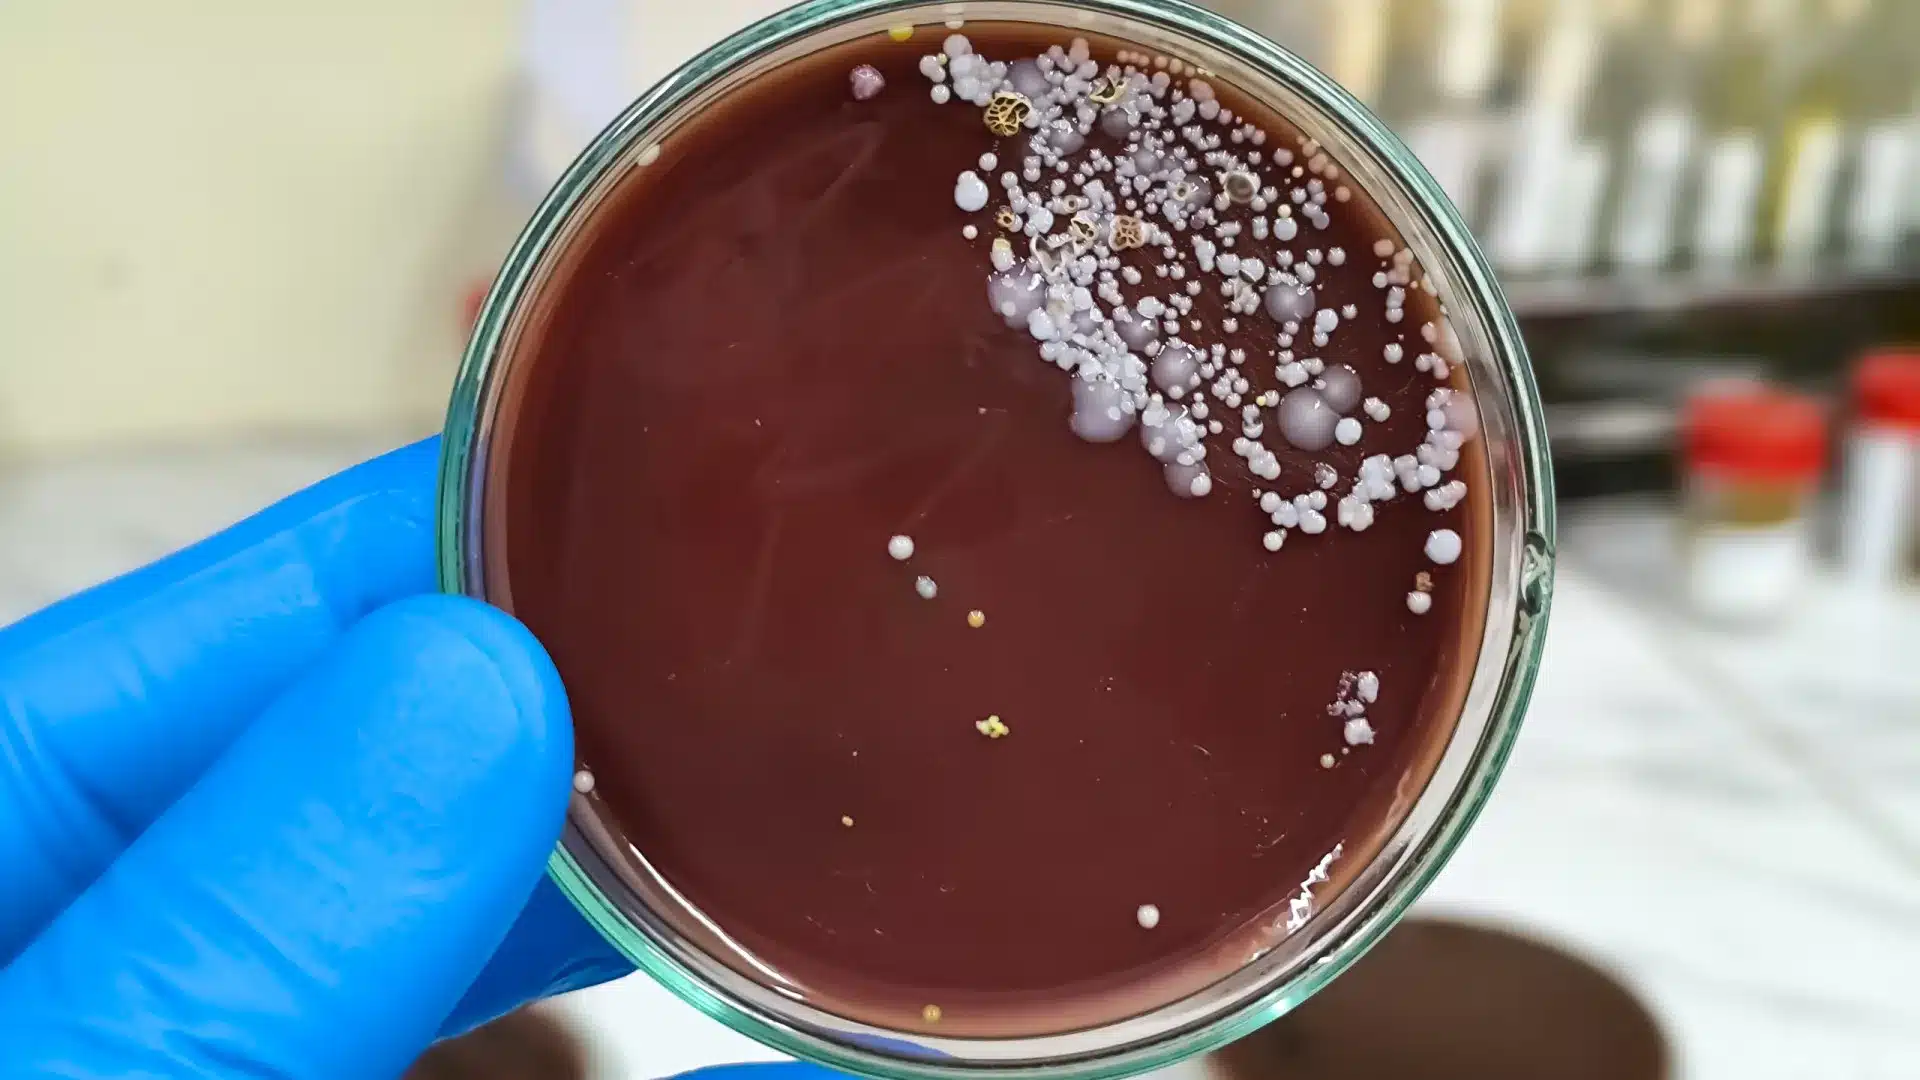
Menace. Premiers cas de 'Candida auris' identifiés au Portugal

Dans un communiqué envoyé aujourd’hui à l’agence Lusa, la FMUP décrit que cette étude identifie les premiers cas de ‘Candida auris’ dans le pays, entraînant des conclusions qui renforcent l’importance de la surveillance hospitalière.
« Il est fondamental que les institutions dédiées à l’enseignement et à la recherche s’articulent avec les hôpitaux et les ULS [Unités Locales de Santé], dans le sens d’une recherche translationnelle intégrée, afin de renforcer la capacité de réponse aux défis émergents en santé publique, basée sur des preuves », affirme Sofia Costa de Oliveira, enseignante à la FMUP qui a coordonné l’étude, dont les résultats ont été publiés dans la revue scientifique Journal of Fungi en octobre 2025.
Huit cas identifiés en 2023 ont été classifiés dans un hôpital de la région Nord, peut-on lire dans le résumé partagé avec Lusa, dans lequel il est précisé qu’aucun des trois décès des cas d’infection invasive rapportés n’était exclusivement associé à l’infection, mais à de sévères comorbidités des patients.
Soulignant qu' »il est important de comprendre que ce champignon se propage à l’hôpital et non dans la communauté », la coordinatrice indique que « son importance en santé publique est principalement liée à la facilité de transmission dans les unités de soins de santé et à la résistance à certains antifongiques, ce qui justifie une surveillance renforcée ».
« La détection précoce de colonisation ou d’infection chez des patients à risque permet une intervention plus efficace et limite la propagation dans les services de santé. Les mesures de contrôle des infections, telles que l’hygiène rigoureuse des mains, la désinfection des surfaces et équipements ainsi que la surveillance en laboratoire, sont cruciales pour réduire la transmission », conclut-elle.
La ‘Candida auris’ est une levure qui peut coloniser la peau et provoquer des infections invasives chez les patients présentant des facteurs de risque, tels que des maladies graves, des traitements invasifs et l’utilisation d’antibiotiques et d’immunosuppresseurs. Considérée comme une menace pour la santé publique mondiale, elle est répandue sur plusieurs continents, touchant environ 60 pays.
Le micro-organisme n’est pas transmis par l’air, mais par contact entre patients, entre professionnels de santé, ou avec des surfaces et équipements contaminés.
Cette espèce se distingue par sa résistance à de nombreux médicaments antifongiques et sa capacité à persister sur les surfaces et équipements, ce qui peut faciliter sa transmission dans les unités de soins de santé.
« La caractérisation des mécanismes impliqués dans la résistance à la thérapeutique antifongique est essentielle pour rechercher des alternatives pharmacologiques plus efficaces. La prochaine étape consistera à explorer l’impact réel des nouvelles mutations détectées sur la progression de l’infection et la résistance antimicrobienne de la ‘Candida auris’, afin de tenter de contrôler cette menace mondiale pour la santé », affirme la professeure.
L’article a résulté d’un travail de recherche qui a également impliqué Isabel Miranda, de la FMUP et RISE-Health, Dolores Pinheiro, José Artur Paiva et João Tiago Guimarães, de la FMUP et de l’ULS São João, Micael Gonçalves, du CESAM, et Sandra Hilário, de la FCUP.
En septembre de l’année dernière, le Centre Européen de Prévention et Contrôle des Maladies (ECDC) a alerté sur la propagation rapide dans les hôpitaux de ce champignon résistant aux médicaments et a demandé des mesures pour stopper sa dissémination.
Dans un communiqué, l’ECDC a indiqué qu’entre 2013 et 2023, plus de 4 000 cas ont été enregistrés dans les pays de l’UE/EEE (incluant l’Islande, le Liechtenstein et la Norvège), soulignant « un saut significatif » en 2023, année où 1 346 cas ont été indiqués dans 18 pays.